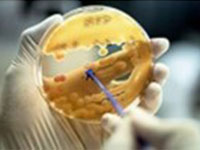

SureTRACE Supplier Partnerships
Our SureTRACE Quality Commitment
The Fisher Scientific channel is committed to providing superior service and meeting or exceeding your product quality, compliance and regulatory requirements.
We understand that quality requirements in the biotech and biopharmaceutical industries are continuously growing, driven by increasing demands from regulatory authorities and tighter international guidelines.
To meet or exceed your evolving needs, we work with key supplier partners who have the capabilities to support and comply with increased levels of traceability or compliance.
As suppliers are a critical element of the supply chain, we are dedicated to using risk management principles to build and maintain relationships with our SureTRACE suppliers.
SureTRACE Supplier Quality Management Performance
Through our Quality Management System and the Quality Agreements put into place with our strategic suppliers, we will assess and monitor performance to ensure the SureTRACE program is supported and maintains compliance with ISO standards.
Learn More About Our Quality Management System

Look for products with the SureTRACE icon to start benefitting from our traceability and quality assurance today.
SureTRACE Supplier Partners
The SureTRACE portfolio is ever expanding to support the critical areas that matter the most to you, offering consumables, chemicals, equipment and instrumentation and supporting you from discovery to production :

Cell Lines, Cell Culture & Bioprocessing

Analytical, Microbial and In-process QC / Release Testing
Purification and Filtration Solutions

Cleanroom Operations – Contamination Control

Formulation, Finish & Fill






























